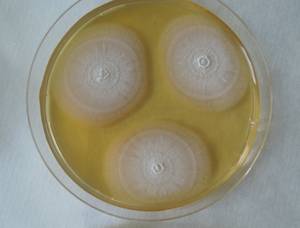
MSU_FS-01946, Район Бу Зяп (Bù Gia Mập district), Bình Phước province (Vietnam)

Total items: 5
Total pages: 1
Organisms

- Specimen ID
- 0000000904960
- Species
- Ovicillium subglobosum
- Strain
- MSU_FS-01947
- Place of isolation
- Район Бу Зяп (Bù Gia Mập district), Bình Phước province (Vietnam)
- Placename
- Бу Зя Мап (Bù Gia Mập)
- Specimen ID
- 0000000904958
- Species
- Ovicillium subglobosum
- Strain
- MSU_FS-01946
- Place of isolation
- Район Бу Зяп (Bù Gia Mập district), Bình Phước province (Vietnam)
- Placename
- Бу Зя Мап (Bù Gia Mập)

- Specimen ID
- 0000000904738
- Species
- Ovicillium subglobosum
- Strain
- MSU_FS-01818
- Place of isolation
- Район Бу Зяп (Bù Gia Mập district), Bình Phước province (Vietnam)
- Placename
- Бу Зя Мап (Bù Gia Mập)

- Specimen ID
- 0000000904432
- Species
- Ovicillium subglobosum
- Strain
- MSU_FS-01552
- Place of isolation
- Район Тан Фу (Tân Phú districts), Đồng Nai province (Vietnam)
- Placename
- Нам Кат Тьен (Nam Cát Tiên)

- Specimen ID
- 0000000904170
- Species
- Ovicillium subglobosum
- Strain
- MSU_FS-01355
- Place of isolation
- Район Лак (Lắk district), Đắk Lắk province (Vietnam)
- Placename
- Бонг Кранг (Bông Krang)